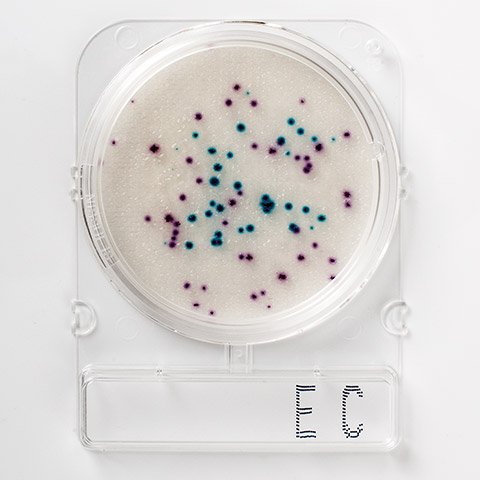
inicio_sobre_leitura
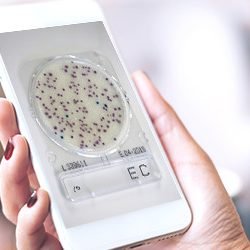
step2 step2

Compact Dry YMR
Bolores leveduras
Incubação YMR: 48 à 72h
Temperatura: 25 ± 2°C
Para mais informações
O Compact Dry é um método de ensaio microbiológico pronto para uso que permite uma perfeita absorção das amostras inoculadas.
Permite quantificar a maioria das bactéricas de interesse para a indústria alimentícia.

Bolores leveduras
Incubação YMR: 48 à 72h
Temperatura: 25 ± 2°C
Bactérias totais
Incubação: 24 ± 3h
Temperatura: 35ºC ± 1ºC
Temperatura p/ matriz láctea: 32ºC ± 1ºC
Quantitativa
Incubação: 24h
Temperatura: 37 ± 1°C
Qualitativa
Enriquecimento: 30 ± 1°C por 24h
Incubação: 37 ± 1°C por 24h
Bolores leveduras
Incubação YM: 3-7 dias
Temperatura: 25 ± 2°C
Salmonella
Incubação: 20 – 24h
Temperatura: 41 ± 0,5°C
Pré enriquecimento: 36 ± 1°C por 22 ± 2h;
Enriquecimento sel.: 41 ± 0,5°C por 22 ± 2h;
Plaqueamento: 41 ± 0,5°C por 22 ± 2h.
Quantitativa
Pré-incubação: 30°C por 1h
Incubação:24-48h
Temperatura: 37 ± 1°C
Qualitativa
Enriquecimento: 30 ± 1°C por 24h
Incubação: 37 ± 1°C por 24-48h
Bacillus cereus
Incubação: 24h
Temperatura: 30 ± 1°C
Enterobactérias
Incubação: 24h
Temperatura: 35 ± 2°C
Staphilococcus aureus
Incubação: 24±2h
Temperatura: 35 ± 2°C
Coliformes totais
Incubação: 18 – 24h
Temperatura: 37 ± 1°C
44°C (coliformes termotolerantes)
Coliformes e E.Coli
Incubação: 24h
Temperatura: 35 ± 2ºC
Bactérias totais
Incubação: 48 ± 3h
Temperatura: 35 ± 2°C
*Requer Android 13.0 ou superior



Tirar uma foto
Smartphone / Câmera Digital
Carregar a imagem
Smartphone / PC

Contar o número de colônias
Cálculo bacteriano automático
Para saber mais sobre o Compact Dry, disponibilizamos um material com todas as informações do produto, para fazer o download, é só preencher o formulário com seu nome + e-mail.
Realizando o download, você se inscreve automaticamente em nossa newsletter.
O conteúdo desta página é protegido.